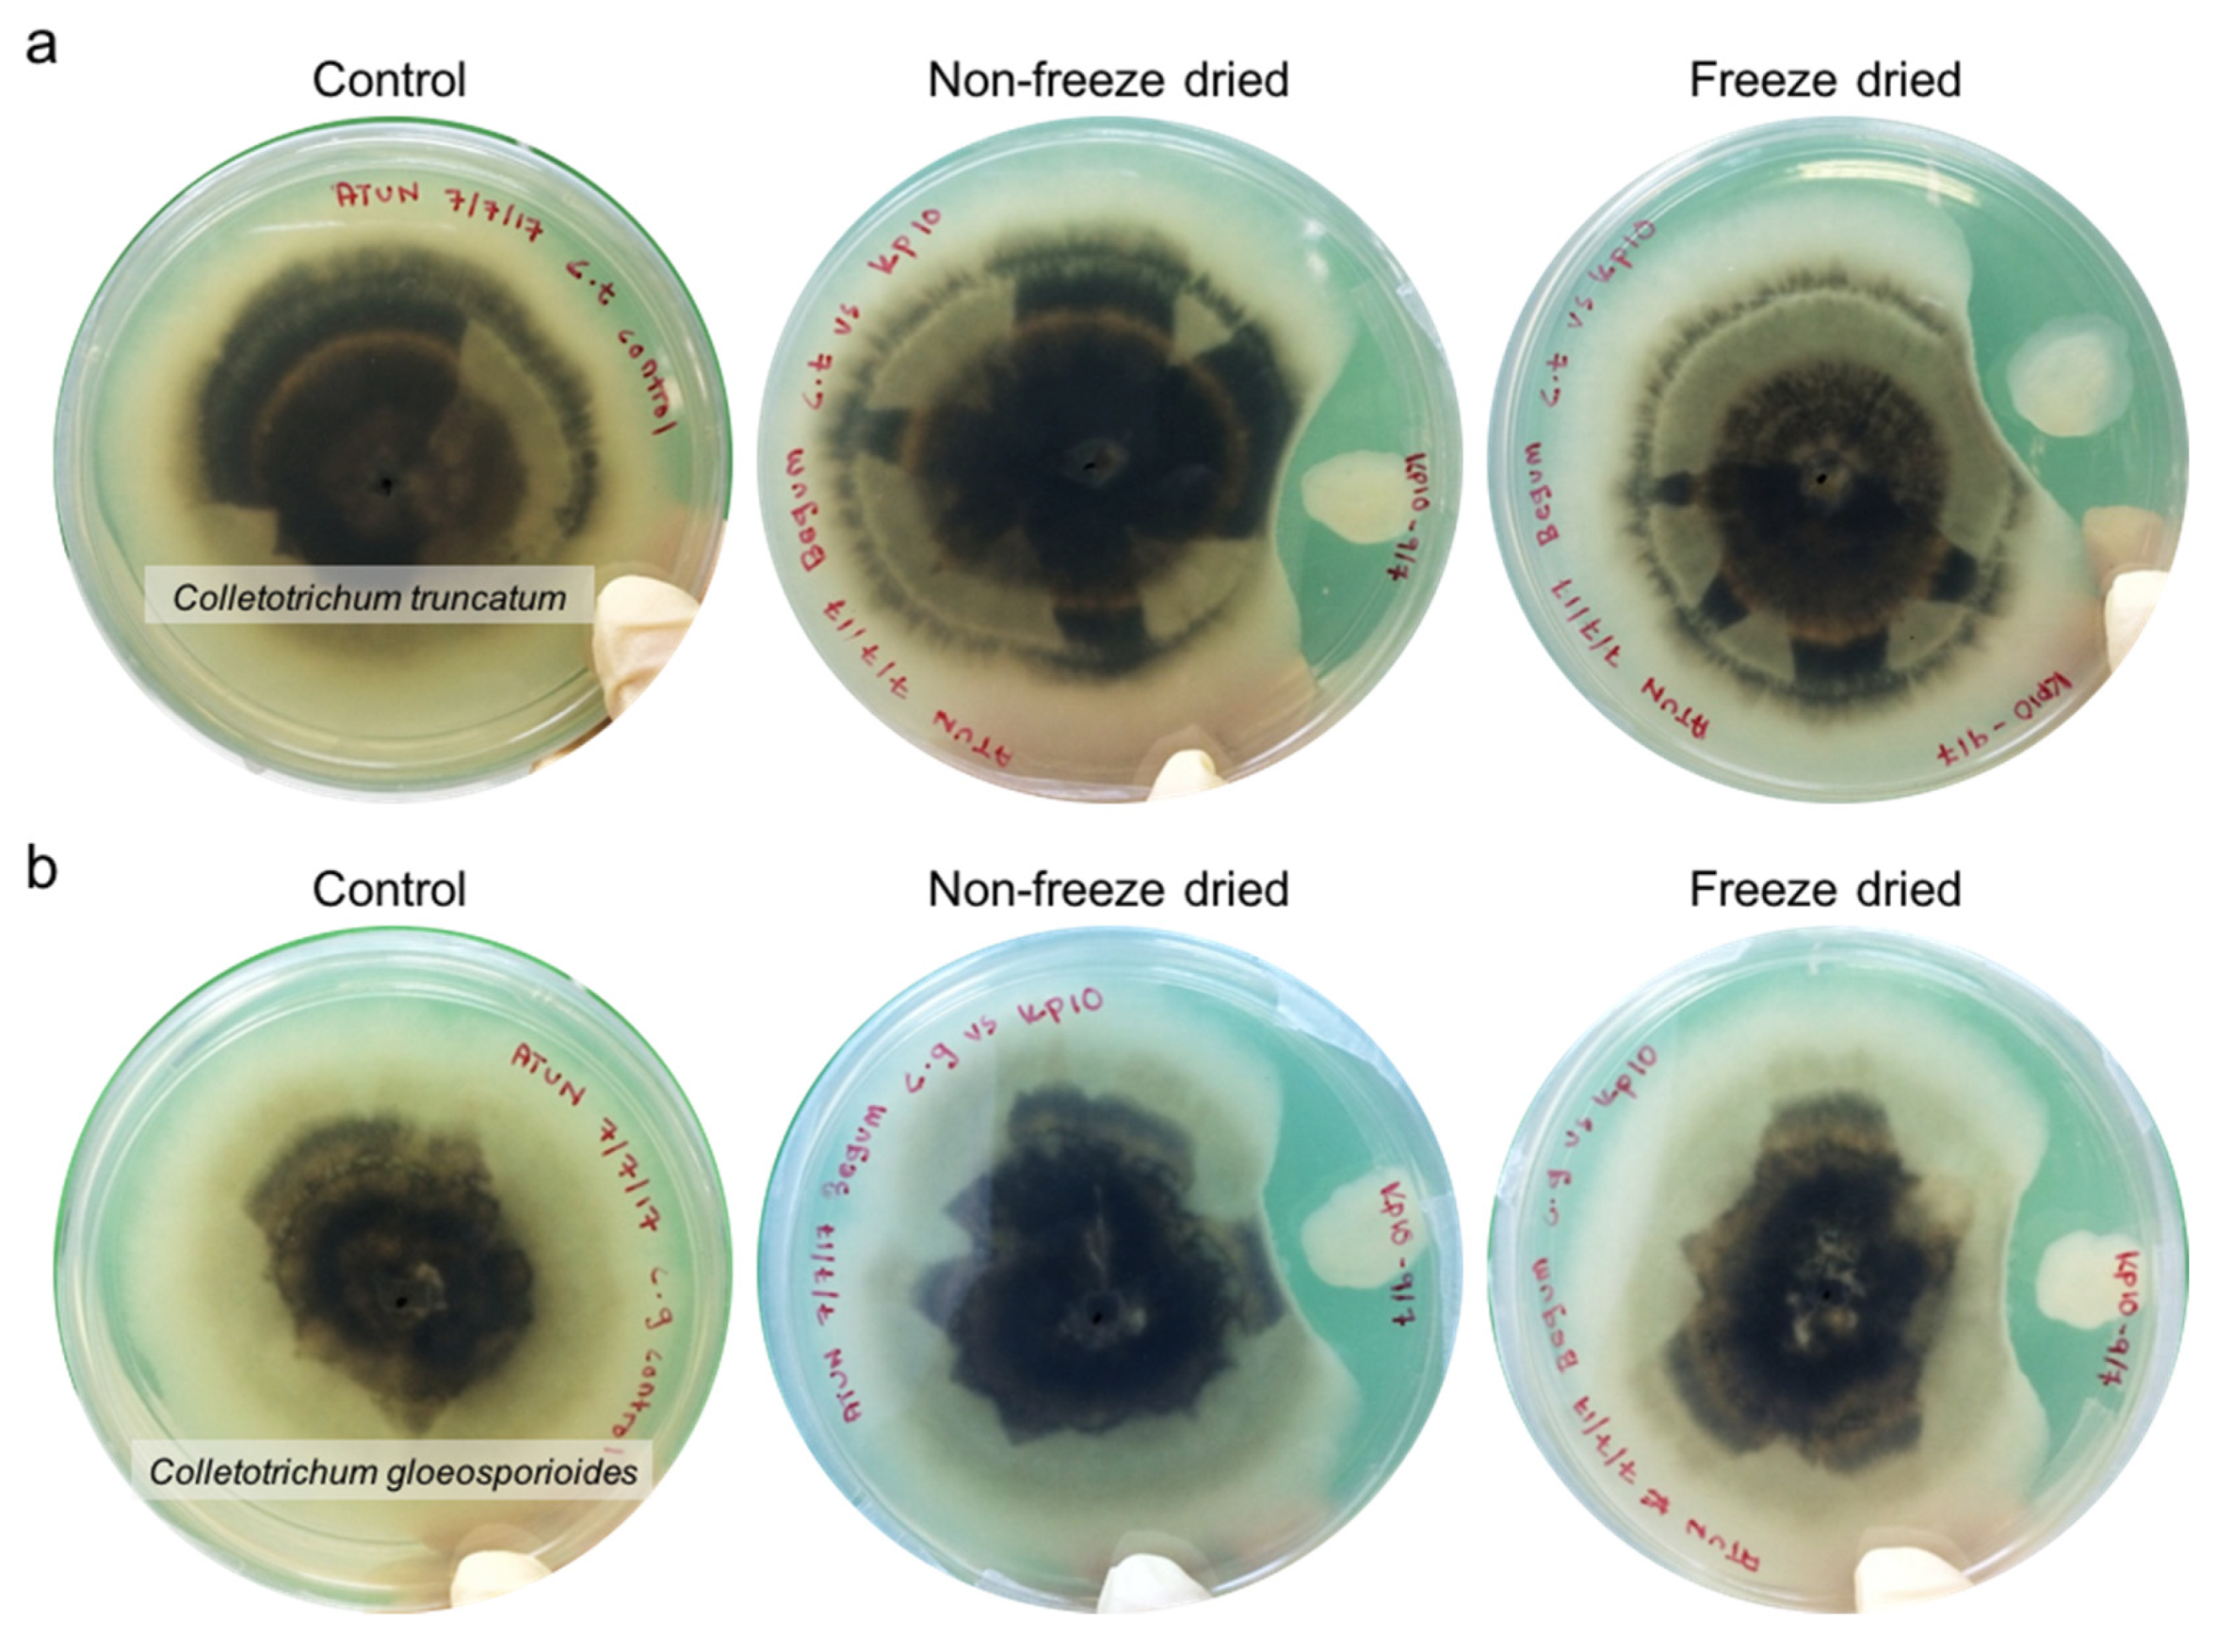
Molecules 25 02618 g003 Molecules 25 02618 g003

Optimization of Protective Agents for The Freeze-Drying of Paenibacillus polymyxa Kp10 as a Potential Biofungicide
Abstract
1. Introduction
2. Results and Discussion
2.1. Cell Growth Curve of P. polymyxa Kp10
2.2. Selection of Protective Agents for Bioformulation of P. polymyxa Kp10
2.3. Optimization of Protective Agent Combination Using RSM
2.4. Antifungal Activity
3. Materials and Methods
3.1. Microorganism and Cell Growth Curve Preparation
3.2. Protective Agents Screening and Preparation of Protective Agents
3.3. Experimental Design for Optimization of Protective Agent Combination Using RSM
3.4. Culture Preparation for Freeze-Drying
3.5. Recovery of Freeze-Dried Cells and Cell Viability Determination
3.6. Antifungal Activity
4. Conclusions
Author Contributions
Funding
Acknowledgements
Conflicts of Interest
References
- Yashoda, K.; Manasa, M.; Vivek, M.N.; Prashith Kekuda, T.R. Inhibitory Effect of Some Plants of Western Ghats of Karnataka against Colletotrichum capsici. Sci. Technol. Arts Res. J. 2014, 3, 76. [Google Scholar] [CrossRef]
- Yusuf, N.; Fazi, S.M.; Ali, N.A.; Fauzi, N.I. Effects of Colletotrichum capsici infection on the growth and antioxidative response on defense mechanisms of Capsicum annuum. Malays. J. Microbiol. 2016, 12, 455–462. [Google Scholar]
- Bale, J.; van Lenteren, J.; Bigler, F. Biological control and sustainable food production. Philos. Trans. R. Soc. B Biol. Sci. 2008, 363, 761–776. [Google Scholar] [CrossRef]
- Timmusk, S.; West, P.V.; Gow, N.A.R.; Huffstutler, R.P. Paenibacillus polymyxa antagonizes oomycete plant pathogens Phytophthora palmivora and Phythium aphanidermatum. J. Appl. Microbiol. 2009, 106, 1473–1481. [Google Scholar] [CrossRef] [PubMed]
- Weselowski, B.; Nathoo, N.; Eastman, A.W.; Macdonald, J.; Yuan, Z.C. Isolation, identification and characterization of Paenibacillus polymyxa CR1 with potentials for biopesticide, biofertilization, biomass degradation and biofuel production. BMC Microbiol. 2016, 16, 244. [Google Scholar] [CrossRef] [PubMed]
- Deng, Y.; Lu, Z.; Lu, F.; Zhang, C.; Wang, Y.; Zhao, H.; Bie, X. Identification of LI-F type antibiotics and di-n-butyl phthalate produced by Paenibacillus polymyxa. J. Microbiol. Meth. 2011, 85, 175–182. [Google Scholar] [CrossRef] [PubMed]
- Lal, S.; Tabacchioni, S. Ecology and biotechnological potential of Paenibacillus polymyxa: A mini review. Indian J. Microbiol. 2009, 49, 2–10. [Google Scholar] [CrossRef]
- Grady, E.N.; MacDonald, J.; Liu, L.; Richman, A.; Yuan, Z.-C. Current knowledge and perspectives of Paenibacillus: A review. Microb. Cell Fact. 2016, 15, 203. [Google Scholar] [CrossRef]
- Liu, Z.; Wei, H.; Li, Y.; Li, S. Optimization of the spray drying of a Paenibacillus polymyxa-based biopesticide on pilot plant and production scales. Biocontrol Sci. Technol. 2014, 24, 37–41. [Google Scholar] [CrossRef]
- Du, N.; Shi, L.; Yuan, Y.; Sun, J.; Shu, S.; Guo, S. Isolation of a potential biocontrol agent Paenibacillus polymyxa NSY50 from vinegar waste compost and its induction of host defense responses against Fusarium wilt of cucumber. Microbiol. Res. 2017, 202, 1–10. [Google Scholar] [CrossRef] [PubMed]
- Allard, S.; Enurah, A.; Strain, E.; Millner, P.; Rideout, S.L.; Brown, E.W.; Zheng, J. In situ evaluation of Paenibacillus alvei in reducing carriage of Salmonella enterica serovar newport on whole tomato plants. Appl. Environ. Microbiol. 2014, 80, 3842–3849. [Google Scholar] [CrossRef] [PubMed]
- Otero, M.C.; Espeche, M.C.; Nader-Macías, M.E. Optimization of the freeze-drying media and survival throughout storage of freeze-dried Lactobacillus gasseri and Lactobacillus delbrueckii subsp. delbrueckii for veterinarian probiotic applications. Process Biochem. 2007, 42, 1406–1411. [Google Scholar] [CrossRef]
- Halim, M.; Mohd Mustafa, N.A.; Othman, M.; Wasoh, H.; Kapri, M.R.; Ariff, A.B. Effect of encapsulant and cryoprotectant on the viability of probiotic Pediococcus acidilactici ATCC 8042 during freeze-drying and exposure to high acidity, bile salts and heat. LWT Food Sci. Technol. 2017, 81, 210–216. [Google Scholar] [CrossRef]
- Oslan, S.N.H.; Halim, M.; Ramle, N.A.; Saad, M.Z.; Tan, J.S.; Kapri, M.R.; Ariff, A.B. Improved stability of live attenuated vaccine gdhA derivative Pasteurella multocida B:2 by freeze drying method for use as animal vaccine. Cryobiology 2017, 79, 1–8. [Google Scholar] [CrossRef] [PubMed]
- Berner, D.; Viernstein, H. Effect of protective agents on the viability of Lactococcus lactis subjected to freeze-thawing and freeze-drying. Sci. Pharm. 2006, 74, 137–149. [Google Scholar] [CrossRef]
- Ming, L.C.; Rahim, R.A.; Wan, H.Y.; Ariff, A.B. Formulation of Protective Agents for Improvement of Lactobacillus salivarius I 24 Survival Rate Subjected to Freeze Drying for Production of Live Cells in Powderized Form. Food Bioprocess Technol. 2009, 2, 431–436. [Google Scholar] [CrossRef]
- Bircher, L.; Geirnaert, A.; Hammes, F.; Lacroix, C.; Schwab, C. Effect of cryopreservation and lyophilization on viability and growth of strict anaerobic human gut microbes. Microb. Biotechnol. 2018, 11, 721–733. [Google Scholar] [CrossRef]
- Zhang, B.; Hui, Y.; Chen, H.; Wan, H. Optimization of cryoprotectants for Streptococcus thermophilus during freeze-drying using Box-Behnken experimental design of response surface methodology. Emir. J. Food Agric. 2017, 29, 256–263. [Google Scholar]
- Carvalho, A.; Teixeira, P.; Gibbs, P.; Carvalho, A.S.; Silva, J.; Ho, P.; Teixeira, P.; Malcata, F.X.; Gibbs, P. Relevant factors for the preparation of freeze- dried lactic acid bacteria. Int. Dairy J. 2004, 14, 835–847. [Google Scholar] [CrossRef]
- Oslan, S.N.H.; Tan, J.S.; Saad, M.Z.; Halim, M.; Mohamed, M.-S.; Ariff, A.B. Influence of amino acids and vitamins on the growth of gdhA derivative Pasteurella multocida B:2 for use as an animal vaccine. Bioprocess Biosyst. Eng. 2019, 42, 355–365. [Google Scholar] [CrossRef]
- Othman, M.; Ariff, A.B.; Wasoh, H.; Kapri, M.R.; Halim, M. Strategies for improving production performance of probiotic Pediococcus acidilactici viable cell by overcoming lactic acid inhibition. AMB Express 2017, 7, 215. [Google Scholar] [CrossRef] [PubMed]
- Ming, L.C.; Halim, M.; Rahim, R.A.; Wan, H.Y.; Ariff, A. Bin Strategies in fed-batch cultivation on the production performance of Lactobacillus salivarius I 24 viable cells. Food Sci. Biotechnol. 2016, 25, 1393–1398. [Google Scholar] [CrossRef] [PubMed]
- Rojas Tapias, D.; Ortiz-Vera, M.; Rivera, D.; Kloepper, J.; Bonilla, R. Evaluation of three methods for preservation of Azotobacter: Freeze-drying, cryopreservation, and immobilization in dry polymers. Univ. Sci. 2013, 18, 129–139. [Google Scholar] [CrossRef]
- Keivani, F.; Mokarram, R.R.; Benis, K.Z.; Gholian, M.M.; Zendeboodi, F.; Zadeh, S.S. External and internal factors affecting survival of probiotic living cells during desiccation. Int. J. Pharm. 2014, 3, 309–316. [Google Scholar]
- Kim, Y.S.; Kotnala, B.; Kim, Y.H.; Jeon, Y. Biological characteristics of Paenibacillus polymyxa GBR-1 involved in root rot of stored Korean ginseng. J. Ginseng Res. 2016, 40, 453–461. [Google Scholar] [CrossRef]
- Corcoran, B.M.; Ross, R.P.; Fitzgerald, G.F.; Stanton, C. Comparative survival of probiotic lactobacilli spray-dried in the presence of prebiotic substances. J. Appl. Microbiol. 2004, 96, 1024–1039. [Google Scholar] [CrossRef]
- Mary, P.; Ochin, D.; Tailliez, R. Growth status of rhizobia in relation to their tolerance to low water activities and desiccation stresses. Soil Biol. Biochem. 1986, 18, 179–184. [Google Scholar] [CrossRef]
- Chen, H.; Tian, M.; Chen, L.; Cui, X.; Meng, J.; Shu, G. Optimization of composite cryoprotectant for freeze-drying Bifidobacterium bifidum BB01 by response surface methodology. Artif. Cells, Nanomed. Biotechnol. 2019, 47, 1559–1569. [Google Scholar] [CrossRef]
- You, Q.; Peng, J.; Xie, Y.; Xin, L.; Zhiguang, T.; Feng, B.; Wang, L.; Weng, M.; Ganlin, C. Optimization of Protective Agents and Freeze-Drying Conditions for Lactobacillus casei LT-L614. J. Biobased Mater. Bioenergy 2019, 13, 123–128. [Google Scholar] [CrossRef]
- Dianawati, D.; Mishra, V.; Shah, N.P. Survival of Bifidobacterium longum 1941 microencapsulated with proteins and sugars after freezing and freeze drying. Food Res. Int. 2013, 51, 503–509. [Google Scholar] [CrossRef]
- King, V.A.E.; Su, J.T. Dehydration of Lactobacillus acidophilus. Process Biochem. 1993, 28, 47–52. [Google Scholar] [CrossRef]
- Hubálek, Z. Protectants used in the cryopreservation of microorganisms. Cryobiology 2003, 46, 205–229. [Google Scholar] [CrossRef]
- Portner, D.C.; Leuschner, R.G.K.; Murray, B.S. Optimising the viability during storage of freeze-dried cell preparations of Campylobacter jejuni. Cryobiology 2007, 54, 265–270. [Google Scholar] [CrossRef] [PubMed]
- Shamekhi, F.; Shuhaimi, M.; Ariff, A.B.; Yazid, A.M. Optimization of a cryoprotective medium for infant formula probiotic applications using response surface methodology. Ann. Microbiol. 2012, 62, 911–921. [Google Scholar] [CrossRef]
- Morgan, C.A.; Herman, N.; White, P.A.; Vesey, G. Preservation of micro-organisms by drying; A review. J. Microbiol. Methods 2006, 66, 183. [Google Scholar] [CrossRef]
- Piszkiewicz, S.; Pielak, G.J. Protecting Enzymes from Stress-Induced Inactivation. Biochemistry 2019, 58, 3825–3833. [Google Scholar] [CrossRef]
- Wong, S.; Kabeir, B.M.; Mustafa, S.; Mohamad, R.; Hussin, A.S.M.; Manap, M.Y. Viability of Bifidobacterium Pseudocatenulatum G4 after Spray-Drying and Freeze-Drying. Microbiol. Insights 2010, 3, 37–43. [Google Scholar] [CrossRef]
- Song, W.; Ma, D.; Wei, X. Original Research Article Assessing cell viability and biochemical stability of freeze-dried Sulphate—Reducing bacteria within different types of cryoprotectants and storage conditions. Int. J. Curr. Microbiol. Appl. Sci. 2014, 3, 659–670. [Google Scholar]
- Naing, K.W.; Anees, M.; Kim, S.J.; Nam, Y.; Kim, Y.C.; Kim, K.Y. Characterization of antifungal activity of Paenibacillus ehimensis KWN38 against soilborne phytopathogenic fungi belonging to various taxonomic groups. Ann. Microbiol. 2014, 64, 55–63. [Google Scholar] [CrossRef]
- Chen, X.; Wang, G.; Xu, M.; Jin, J.; Liu, X. Antifungal peptide produced by Paenibacillus polymyxa BRF-1 isolated from soybean rhizosphere. African J. Microbiol. Res. 2010, 4, 2692–2698. [Google Scholar]
- Jeong, H.; Choi, S.K.; Ryu, C.M.; Park, S.H. Chronicle of a soil bacterium: Paenibacillus polymyxa E681 as a Tiny Guardian of Plant and Human Health. Front. Microbiol. 2019, 10, 1–16. [Google Scholar] [CrossRef] [PubMed]
- Karpunina, L.V.; Mel’nikova, U.Y.; Konnova, S.A. Biological role of lectins from the nitrogen-fixing Paenibacillus polymyxa strain 1460 during bacterial-plant-root interactions. Curr. Microbiol. 2003, 47, 376–378. [Google Scholar] [CrossRef] [PubMed]
- Raza, W.; Hongsheng, W.; Qirong, S. Response of Paenibacillus polymyxa to iron: Alternations in cellular chemical composition and the production of fusaricidin type antimicrobial compounds. Brazilian Arch. Biol. Technol. 2010, 53, 1145–1154. [Google Scholar] [CrossRef]
- Begum, M.M.; Sariah, M.; Abidin, M.A.Z.; Puteh, A.B.; Rahman, M.A. Antagonistic potential of selected fungal and bacterial biocontrol agents against Colletotrichum truncatum of soybean seeds. Pertanika J. Trop. Agric. Sci. 2008, 31, 45–53. [Google Scholar]
Sample Availability: Samples of the bacteria are not available from the authors. |

| Protective Agent | Viable Cell (log CFU/mL) | Survival Rate (%) | |
|---|---|---|---|
| * Before Freeze Drying | After Freeze Drying | ||
| Skim milk (20% w/v) | 8.050 | 7.185 | 89.26 |
| Lactose (10% w/v) | 8.000 | 7.022 | 87.78 |
| Sucrose (30% w/v) | 8.097 | 6.732 | 83.14 |
| Soytone (15% w/v) | 7.574 | 5.236 | 69.13 |
| Distilled water (control) | 7.468 | 4.648 | 62.24 |
| Sum of Squares | df | Mean Square | F-Value | p-Value (Prob > F) | ||
|---|---|---|---|---|---|---|
| Mean vs. Total | 661.95 | 1 | 661.95 | |||
| Linear vs. Mean | 2.590 × 10−4 | 3 | 8.632 × 10−5 | 0.022 | 0.9954 | |
| 2FI vs. Linear | 4.605 × 10−3 | 3 | 1.535 × 10−3 | 0.34 | 0.7960 | |
| Quadratic vs. 2FI | 0.058 | 3 | 0.019 | 505.45 | <0.0001 | Suggested |
| Cubic vs. Quadratic | 1.940 × 10−4 | 4 | 4.851 × 10−5 | 1.54 | 0.3032 | Aliased |
| Residual | 1.892 × 10−4 | 6 | 3.154 × 10−5 | |||
| Total | 662.02 | 20 | 33.10 |
| Source | Sum of Squares | df | Mean Square | F value | p-Value (Prob > F) | |
|---|---|---|---|---|---|---|
| Model | 0.063 | 9 | 6.998 × 10−3 | 182.58 | <0.0001 | Significant |
| A-sucrose | 1.231 × 10−4 | 1 | 1.231 × 10−4 | 3.21 | 0.1034 | |
| B-skim milk | 9.761 × 10−6 | 1 | 9.761 × 10−6 | 0.25 | 0.6247 | |
| C-lactose | 1.261 × 10−4 | 1 | 1.261 × 10−4 | 3.29 | 0.0998 | |
| AB | 3.001 × 10−4 | 1 | 3.001 × 10−4 | 7.83 | 0.0189 | |
| AC | 4.005 × 10−3 | 1 | 4.005 × 10−3 | 104.49 | <0.0001 | |
| BC | 3.001 × 10−4 | 1 | 3.001 × 10−4 | 7.83 | 0.0189 | |
| A2 | 0.017 | 1 | 0.017 | 435.37 | <0.0001 | |
| B2 | 0.015 | 1 | 0.015 | 399.93 | <0.0001 | |
| C2 | 0.037 | 1 | 0.037 | 957.67 | <0.0001 | |
| Residual | 3.833 × 10−4 | 10 | 3.833 × 10−5 | |||
| Lack of Fit | 2.985 × 10−4 | 5 | 5.969 × 10−5 | 3.52 | 0.0968 | Not significant |
| Pure Error | 8.483 × 10−5 | 5 | 1.697 × 10−5 | |||
| Cor Total | 0.063 | 19 |
| Fungal Pathogen | Non-Freeze-Dried | Freeze-dried | ||
|---|---|---|---|---|
| Inhibition Distance (mm) | Antagonism (PIRG) | Inhibition Distance (mm) | Antagonism (PIRG) | |
| Colletotrichum truncatum | 13.03 | 62.80% | 13.95 | 60.18% |
| Colletotrichum gloeosporioides | 14.8 | 60.11% | 12.42 | 66.52% |
| Run | Type | Factor 1 (X1) | Factor 2 (X2) | Factor 3 (X3) |
|---|---|---|---|---|
| Sucrose | Skim Milk | Lactose | ||
| 1 | Center | 0 (27.5%) | 0 (20%) | 0 (10%) |
| 2 | Center | 0 (27. 5%) | 0 (20%) | 0 (10%) |
| 3 | Center | 0 (27.5%) | 0 (20%) | 0 (10%) |
| 4 | Center | 0 (27.5%) | 0 (20%) | 0 (10%) |
| 5 | Center | 0 (27.5%) | 0 (20%) | 0 (10%) |
| 6 | Center | 0 (27.5%) | 0 (20%) | 0 (10%) |
| 7 | Axial | 0 (27.5%) | 0 (20%) | 1.682 (18%) |
| 8 | Axial | 0 (27.5%) | 0 (20%) | −1.682 (2%) |
| 9 | Axial | −1.682 (6.48%) | 0 (20%) | 0 (10%) |
| 10 | Axial | 1.682 (48.52%) | 0 (20%) | 0 (10%) |
| 11 | Axial | 0 (27.5%) | 1.682 (37%) | 0 (10%) |
| 12 | Fact | 0 (27.5%) | −1.682 (3%) | 0 (10%) |
| 13 | Fact | −1 (15%) | 1 (30%) | −1 (5%) |
| 14 | Fact | 1 (40%) | −1 (10%) | 1 (15%) |
| 15 | Fact | −1 (15%) | −1 (10%) | −1 (5%) |
| 16 | Fact | 1 (40%) | 1 (30%) | 1 (15%) |
| 17 | Fact | −1 (15%) | −1 (10%) | 1 (15%) |
| 18 | Fact | −1 (15%) | 1 (30%) | 1 (15%) |
| 19 | Fact | 1 (40%) | −1 (10%) | −1 (5%) |
| 20 | Fact | 1 (40%) | 1 (30%) | −1 (5%) |
| Factor | Symbol | Actual Factor Level at Coded Factor of | ||||
|---|---|---|---|---|---|---|
| −1.682 | −1 | 0 | 1 | 1.682 | ||
| Skim milk (%) | X1 | 3.18 | 10.00 | 20.00 | 30.00 | 36.82 |
| Lactose (%) | X2 | 1.59 | 5.00 | 10.00 | 15.00 | 18.41 |
| Sucrose (%) | X3 | 6.48 | 15.00 | 27.50 | 40.00 | 48.52 |
© 2020 by the authors. Licensee MDPI, Basel, Switzerland. This article is an open access article distributed under the terms and conditions of the Creative Commons Attribution (CC BY) license (http://creativecommons.org/licenses/by/4.0/).
Share and Cite
Nasran, H.S.; Mohd Yusof, H.; Halim, M.; Abdul Rahman, N. Optimization of Protective Agents for The Freeze-Drying of Paenibacillus polymyxa Kp10 as a Potential Biofungicide. Molecules 2020, 25, 2618. https://doi.org/10.3390/molecules25112618
Nasran HS, Mohd Yusof H, Halim M, Abdul Rahman N. Optimization of Protective Agents for The Freeze-Drying of Paenibacillus polymyxa Kp10 as a Potential Biofungicide. Molecules. 2020; 25(11):2618. https://doi.org/10.3390/molecules25112618
Chicago/Turabian StyleNasran, Hayatun Syamila, Hidayat Mohd Yusof, Murni Halim, and Nor’Aini Abdul Rahman. 2020. "Optimization of Protective Agents for The Freeze-Drying of Paenibacillus polymyxa Kp10 as a Potential Biofungicide" Molecules 25, no. 11: 2618. https://doi.org/10.3390/molecules25112618
APA StyleNasran, H. S., Mohd Yusof, H., Halim, M., & Abdul Rahman, N. (2020). Optimization of Protective Agents for The Freeze-Drying of Paenibacillus polymyxa Kp10 as a Potential Biofungicide. Molecules, 25(11), 2618. https://doi.org/10.3390/molecules25112618






